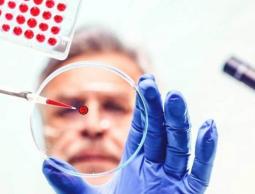
thumb (12)

كشفت إحدى الشركات الأميركية عن علاج جيني جديد يشفي حالات السرطان المتأخرة، التي فشل علاجها بالكيماوي والإشعاع.
ويعمل العلاج على تنشيط الجهاز المناعي لجسم المريض، وقد شفي ثلث من خضعوا لتجربته من مرضى حالات سرطان ليمفاوي.
وتسمى طريقة العلاج الجديدة كار-تي CAR-T ونشرت شركة "كايت فارما" نتائج تجربة العلاج على مدى 6 أشهر، حيث شفي بشكل كامل 36 مريضا من بين 101 مريض خضعوا للعلاج، بينما تراجع الورم في 10 مرضى آخرين.
وتعتمد عملية العلاج على استخلاص الخلايا المناعية (T-cells) من دم المريض ثم هندستها وراثيا في المعمل لتتعامل بشكل أفضل مع الخلايا السرطانية.
والمعروف أن سبب عدم القدرة على علاج السرطان أن الخلايا السرطانية تتمكن من تفادي الخلايا المناعية وتراوغ الجهاز المناعي للجسم بحيث لا يتخلص منها فتنمو وتتكاثر بسرعة.
ومع تنشيط الخلايا المناعية (تي) لتصبح (كار-تي) تتمكن من مهاجمة الخلايا السرطانية بقوة، وتعمل على شفاء المرضى الذين لا يجدي معهم العلاج الكيماوي أو الإشعاعي.
لكن الأضرار الجانبية لتلك الطريقة العلاجية غير معروفة بعد، وإن كان الباحثون الذين طوروا الطريقة العلاجية يقولون إن من تستخدم معهم ليس لديهم فرصة أفضل، إذ غالبا ما يكونوا استنفدوا كل طرق العلاج وأصبح مرضهم في حالة متأخرة بحيث لا يعيشون أكثر من أشهر قليلة.
وكانت شركات أخرى، مثل جونو ثيرابيوتك، أوقفت تجارب تلك الطريقة العلاجية بعد وفاة المرضى من العلاج وليس من السرطان.
وفي التجربة المذكورة، ظهرت أعراض خطيرة على 13 مريضا منها النشاط الزائد عن الحد للجهاز المناعي أو الأنيميا أو غيرها من أمراض الدم، وأعراض أخرى ظهرت على ثلث المرضى في التجربة كلها عصبية مثل الاضطراب والرعشة وصعوبة الكلام.
وفي تجربة الشركة توفي مريضان من بين المئة وواحد بسبب أعراض العلاج.